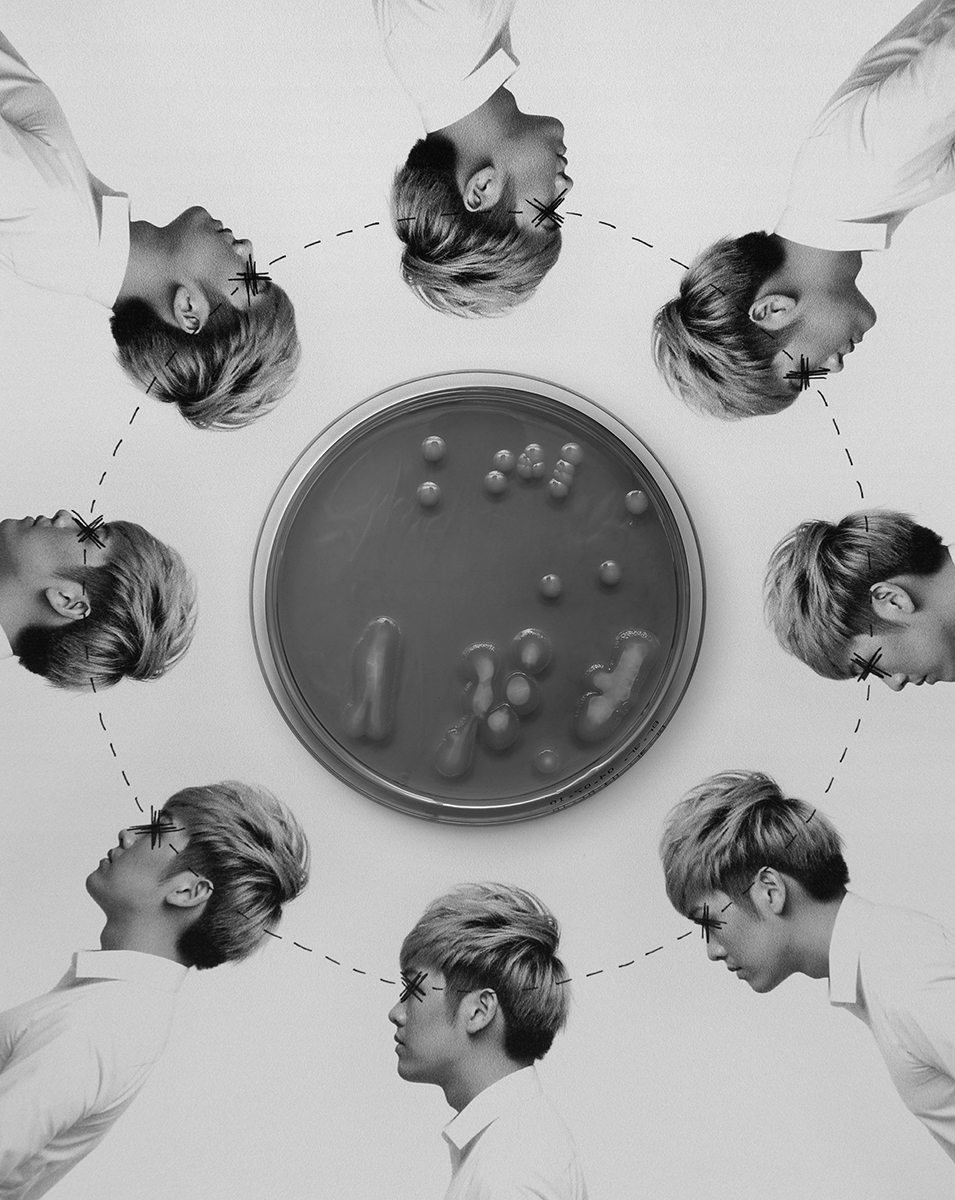

Self Portrait
P H O T O G R A P H Y & M O V I N G I M A G E
In 2018, Riddick Douglas Ning collaborated with Jase and Oscar to publish a book titled Self Portrait – Whatever You Say. While the trio explored themes around humanity, the creative roles were distinctly divided. Jase authored the text, Oscar produced the illustrations, and Ning contributed all photographic elements. For the project, Ning created a range of images, including a series of photo collages, microscopic photographs, and thematic visuals for each chapter.
The photo collages formed the central body of Ning’s contribution. At a time when most collages are produced through digital software, he intentionally returned to a hands‑on approach. The project offered him complete creative freedom, and he chose to step away from his usual professional techniques. He printed the photographs using an ordinary document printer, then cut, crushed, and drew directly onto the prints. This physical process allowed him to engage with the traditional foundations of collage-making. After the interventions were completed, Ning reproduced the collages through flat-copying and performed the final retouching digitally. The repeated cycle of printing and digitisation purposely reduced image clarity, which introduced a raw and tactile quality. This aesthetic supported the book’s inquiry into human emotion and the complexities of the human condition.
This project also marked the first time Ning incorporated archival materials from public-domain collections, including resources from the New York Public Library. These historical references enriched the visual language of the work and expanded the conceptual depth of the book.
Year
2018
Publication
Self Portrait – Whatever You Say, 2018, HK
[ISBN:978-988-78027-9-2]
Position
Photographer
Book Designer
Video Director & Editor